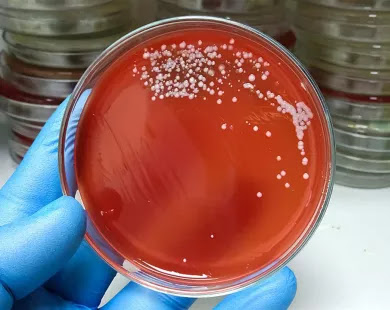

ΕΟΔΥ: 23 θάνατοι από στρεπτόκοκκο στην Ελλάδα από το 2023 μέχρι σήμερα
ΕΘΝΙΚΟΣ ΟΡΓΑΝΙΣΜΟΣ ΔΗΜΟΣΙΑΣ ΥΓΕΙΑΣ
Από την αρχή του έτους 2023 και μέχρι σήμερα, έχουν δηλωθεί στον ΕΟΔΥ 94 περιστατικά με λοίμωξη από διεισδυτικό στρεπτόκοκκο ομάδας Α σε παιδιά και ενήλικες
Ορισμένες ευρωπαϊκές χώρες κατέγραψαν εντός του έτους 2023 αύξηση στον αριθμό των περιστατικών διεισδυτικής λοίμωξης από στρεπτόκοκκο της ομάδας Α (iGAS) ιδιαίτερα σε παιδιά ηλικίας κάτω των 10 ετών. Το Ευρωπαϊκό Κέντρο Ελέγχου & Πρόληψης Νοσημάτων εκτίμησε ότι ο κίνδυνος για το γενικό πληθυσμό είναι χαμηλός, δεδομένου ότι η αύξηση των περιστατικών iGAS είναι σχετικά μικρή. Λόγω της αύξησης των κρουσμάτων iGAS διεθνώς, ο Εθνικός Οργανισμός Δημόσιας Υγείας (ΕΟΔΥ) έχει ενημερώσει τις Υπηρεσίες Υγείας της χώρας μας να δηλώνουν όλα τα περιστατικά iGAS.
Από την αρχή του έτους 2023 και μέχρι σήμερα έχουν δηλωθεί στον ΕΟΔΥ 94 περιστατικά με λοίμωξη από διεισδυτικό στρεπτόκοκκο ομάδας Α σε παιδιά και ενήλικες. Μεταξύ των περιστατικών περιλαμβάνονται και 23 θάνατοι, εκ των οποίων 11 σε παιδιά ηλικίας κάτω των 10 ετών. Πρόσφατα καταγράφηκαν 2 περιστατικά διεισδυτικής νόσου από στρεπτόκοκκο της ομάδας Α εκ των οποίων το 1 κατέληξε, στην ΠΕ Ανατολικής Μακεδονίας & Θράκης.
Όσα πρέπει να γνωρίζετε
Ο β-αιμολυτικός στρεπτόκοκκος της ομάδας Α (GAS) είναι η συνηθέστερη αιτία βακτηριακής φαρυγγίτιδας σε παιδιά σχολικής ηλικίας.Σε σπάνιες περιπτώσεις, ενώ μπορεί να εμφανιστεί αρχικά, με μη ειδικά συμπτώματα (πυρετό, γενική κόπωση, απώλεια όρεξης), στη συνέχεια μπορεί να προκαλέσει σοβαρή και απειλητική για τη ζωή διεισδυτική λοίμωξη. Η συχνότητα εμφάνισης της φαρυγγίτιδας από GAS συνήθως κορυφώνεται κατά τους χειμερινούς μήνες και τις αρχές της άνοιξης και συχνάαναφέρονται συρροές κρουσμάτων σε νηπιαγωγεία και σχολεία. Ο εργαστηριακός έλεγχος πραγματοποιείται με την ταχεία ανίχνευση αντιγόνου του πυογόνου στρεπτοκόκκου στο φάρυγγα (streptest) και με καλλιέργεια φαρυγγικού επιχρίσματος που συστήνεται να λαμβάνονται από επαγγελματία υγείας. Τα παιδιά με ιογενείς λοιμώξεις όπως η γρίπη, διατρέχουν υψηλότερο κίνδυνο να αναπτύξουν λοίμωξη από iGAS.
Η έγκαιρη αναγνώριση της λοίμωξης από iGAS και η άμεση έναρξη αντιμικροβιακής και υποστηρικτικής θεραπείας για τα παιδιά που νοσούν είναι εξαιρετικά σημαντική για την αίσια έκβαση της νόσου. Επίσης, θα πρέπει να εντοπίζονται οι στενές επαφές των περιπτώσεων iGAS στο οικιακό και σχολικό περιβάλλον, να εκτιμάται η κατάστασή τους και να αντιμετωπίζονται σύμφωνα με τις κατευθυντήριες οδηγίες με χορήγηση προφυλακτικής αντιμικροβιακής αγωγής όπου ενδείκνυται. Για την ολοκληρωμένη και επιτυχή διαχείριση των περιστατικών iGAS απαιτείται η ευαισθητοποίηση του πληθυσμού, η εγρήγορση των επαγγελματιών υγείας καθώς και των εμπλεκομένων φορέων.
|
ΑπάντησηΠροώθηση
|





